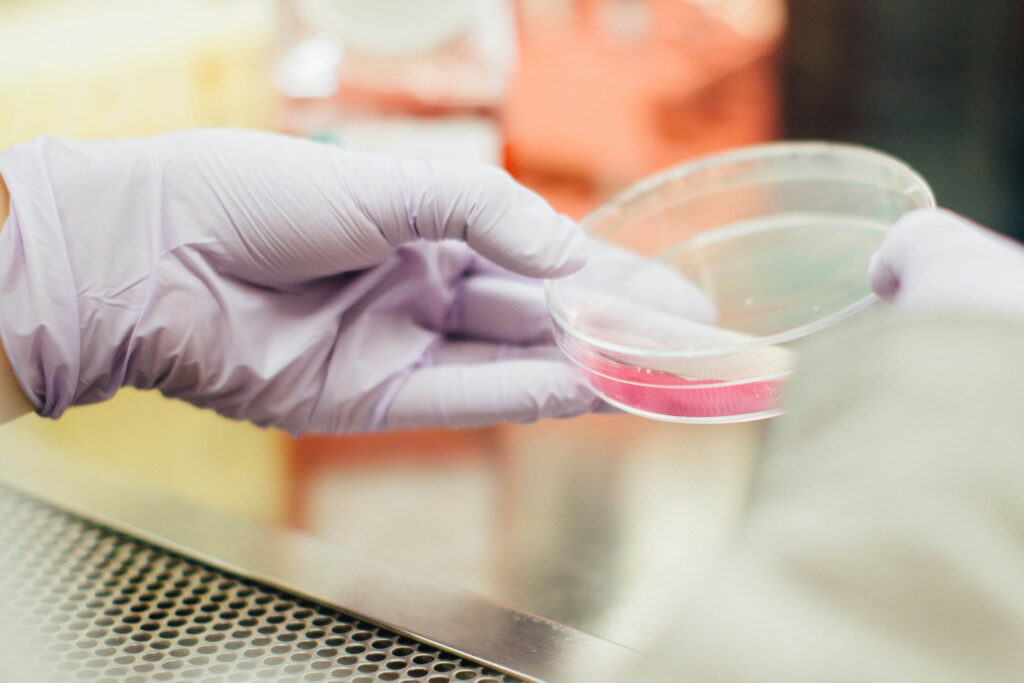

Nature holds wealth law releases it responsibly. We represent mining companies, investors, and regulators in….
Water is life but without governance, it becomes scarcity. At Zaki & Partners, we support governments, utilities….
Health is a public good, but it requires private precision. We counsel hospitals, medical chains, insurers, and investors….
Agriculture is not only cultivation, it is national security….
Food security is the law of survival. At Zaki & Partners, we help governments and private investors establish national….
Transport is the circulation system of civilization….
Supply chains are the veins of the global economy. We design contracts, compliance systems , and governance ….
Tourism is diplomacy in motion a sector that reflects national image and international trust At Zaki & Partners, we….